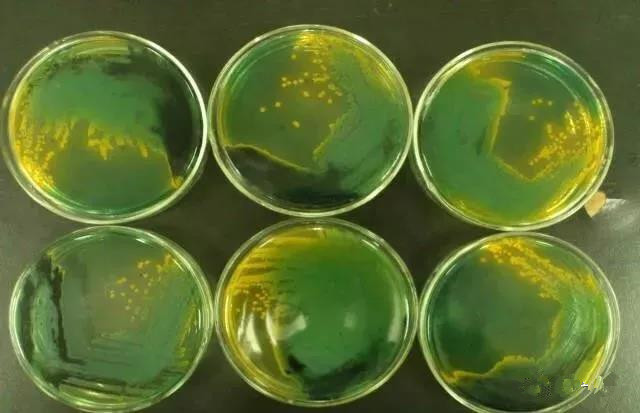

从致病原因来说,弧菌病是细菌感染;病毒病是病毒感染。
当虾发病时,能够准确地判断是弧菌病还是病毒,就是非常关键的一步。因为,两种不同类型的病的传播途径、处理思路都不尽相同。
我们先说说两类疾病的现场辨别:
1、 致病部位:
a) 弧菌病:都是攻击某个局部位置。例如,黑斑病攻击了甲壳;黑腮病和黄腮病攻击了腮部,断须、烂眼、烂尾等也都是单一部位;就算EMS,也是只攻击消化器官和系统:肝脏和肠道;现在流行的白便病攻击的是肠道。
b) 病毒病:病毒往往是多个部位同时攻击。例如,白斑病毒和红体病毒病的共同症状就是头胸甲易剥离、肝脏萎缩、肠道发红、烂鳃、肌肉发白。不同的表现症状:红体病毒病体色发红,偶尔甲壳内表皮有黑斑;白斑病毒病甲壳上有白斑。
c) 所以,一个相对初步的判断方法是,通过被攻击的部位初步来诊断:只出现单一器官或组织的发生病症的,判断为弧菌病;出现多个器官或组织同时发生病症,可判断为病毒病。
2、 生长阶段:根据刚发病时,病虾的规格,也可以快速排除某些疾病。
a) 弧菌病:一批发病的虾,大、中、小虾各种规格都有。因为,弧菌病的发生通常是体内的弧菌累积到临界量后,再爆发。而在同一池塘内的各种规格的虾,都处于同样的养殖水体环境中,其体内的弧菌数量或比率基本上都差不多。所以,一批发病的虾,在各种规格上都会出现;
b) 病毒病:一天发病的虾经常是体弱、大虾。病毒病的发生,首先是抗病力差的弱虾先发病死亡;病虾死亡后,被健康虾吃掉而染病,随后引起几何级的爆发。其主要传播途径是经口传播,简单来讲就是通过虾吃虾传播扩散的。
刚开始发病的虾并不多,但病虾死后,会被大群的健康虾抢着吃,而先抢到的都是那些大虾,小中虾根本挤不进去,所以,发现发病时,往往都是大虾。一般来说,如果在已发病的塘内看到病虾有大有小,并确诊是病毒,那么可以大胆地说。这口塘不是当天发病的,因为一天发病的病毒病虾都会是大虾。
3、 离水试验:把病虾抓起来,放在手掌上30秒左右,再放回水里观察。
a) 弧菌病:病虾能很快站立起来,并开始游动;
b) 病毒病:病虾则多是侧躺,没多久就死亡。
4、 涂板培养
a) 目前,弧菌快速涂板培养以及很方便。有专业的涂板出售,价格也不贵。24小时就可以出结果。
b) 弧菌在专门的培养基上是可以培养出来的,这使现场判断的准确性也大大提升。甚至,可以帮助你判断弧菌病的“严重程度”,可以以菌落大小、密度等估算。菌落数多、密度大,则肯定是弧菌病爆发;如果只有几个菌落,且小,则弧菌可能不是主要致病菌。
c) 病毒,在细菌培养基上是培养不出来的。
大量研究表明,弧菌是一种条件致病菌,它在养殖水体中的生长繁殖条件是:低溶解氧,0.3%~2%的中低盐度水体,有机物丰富,底质恶化的水环境。
实际上,自然水体和养殖水体中本身就都有弧菌,弧菌可谓“无处不在”,是自然环境中的常在菌。在水产养殖过程中,即使南美白对虾苗种“不带弧菌”,放入虾塘后,虾苗也会迅速“被弧菌感染”,只不过弧菌是条件性致病菌,条件“不具备”,不会发病。
目前发现弧菌有91种。常见的弧菌属有36种,其中致病性弧菌就有12种。
虾类常见的致病弧菌: 副溶血弧菌、溶藻弧菌、鳗弧菌、创伤弧菌、河弧菌、哈维氏弧菌及杀对虾弧菌(主要见于日本对虾)。
菌落特征:在TCBS平板上,呈黄色的菌落有可能是溶藻弧菌、麦氏弧菌或霍乱弧菌等;呈米黄色的有可能是河弧菌;绿色是副溶血弧菌。
 从防治的角度看
弧菌病:可以预防与治疗,并且治疗有效。
病毒病:只可以预防,治疗基本无效。
所以,尽管许多水产养殖者视弧菌为南美白对虾养殖的“一杀手”,但个人看来,相对于病毒病,还不是那么“吓人”。及时发现、及时治疗,是可以得到管控的。
我们建议,在水体监测中,采用总菌数与弧菌数同时定期监测,及时分析的做法。可以做到及时发现弧菌预警,提前调整预防和控制措施。
据科研数据表明,当所测绿菌达弧菌总数1/3以上的塘,80%的虾塘会爆发疾病。所以,在实际生产中也是可以参考的一个重要指标。
秋季对虾病害的预防方法
入秋以后,南美白对虾养殖与夏季高温期有了很大差异。随着昼夜温差加大大,水质变化也较大,因此,对虾应激大,易诱发弧菌病和病毒病。
在变温期,尤其是水温在24~26℃之间,如转季的4、5月份,以及9、10月份,这四个月是病毒、弧菌爆发集中的月份。对虾肠炎、偷死、白便也是这个季节的高发病害。一旦对虾肝胰腺出现问题,抵抗力就会随之下降,弧菌、病毒易感染,造成多种疾病同时并发,治疗相当困难。
具体做法建议:
1、秋虾、冬棚虾放苗,还是在虾苗的选择上要慎重、慎重、再慎重。因为,这一部分经常不掌握在养成塘的养殖场手中,有的时候只能是“被选择”。不管如何,还是要在苗场、苗种、批次上多加考虑。
2、入秋后,水质由于季节性的水体中藻类、菌类的快速变化,各种指标也会快速变化。这对养殖过程中的水质稳定和水体溶解氧含量保持影响很大,也是这一阶段的关键。水质稳定和充足的溶氧,意味着水体保持着适于白对虾健康生长的状态,利于致病菌抵御。
3、合理投喂营养均衡的饲料,及时补充多维电解质,拌喂有益菌以保肝健肠,保持白对虾健康状态,是抵御疾病关键的体质保证。
4、采取有效的生物措施,尽量不使用抗生素等药物,建立适于白对虾自身抗病能力提高的稳定生物环境。一是减少/控制致病菌在养殖水体中的比例,使其无法达到致病临界值;二是减少/控制/抵抗致病菌在白对虾体内的致病作用。这就要求白对虾的肝胰腺、肠道保持健康状态,对致病菌的抵抗力提高。
生物控制弧菌
既然弧菌是水体中的常见菌,我们也就没必要非要“杀灭”弧菌,况且实际上我们也办不到。
换一个思路:采取一些方法,将弧菌控制在“不致病”的范围内,只要不影响对虾生长就可以了。 因此,尽量采取一些生物技术集成,保持对虾相对的“自然状态”,更有利于建立水生动物自身的疾病抵抗力。
建议:
1、 放养健康的虾苗,减少因弱苗导致虾易感病菌的情况。
2、 放苗后,就要定期检测弧菌,将这个工作作为日常管理程序执行。建议每周检测一次,这是一般养殖场可以接受的操作。
3、 检测做记录,与其它水质测定、微生物测定数据做分析。
4、 控制弧菌,尽量采用菌相+藻相+蛭弧菌的生物控制方案。不到非用不可,避免使用消毒剂。
5、 水质和底质管理是弧菌防控的关键。不良的水体,才会诱发弧菌危害。
6、 加大增氧,提高水体溶解氧含量,对控制弧菌有明显效果。
这是噬菌蛭弧菌进入弧菌细胞内,并形成四个增殖体,将弧菌细胞破坏的生物学机制模型图示。
目前,利用微生物进行水质处理与病害防治,业已证明是一种绿色环保、有效的病害防治技术与方法,在国内外均有大量的报道。“生物防治”,由于现代生物技术的快速进步,正在成为一种“行之有效”的措施。
近些年,我们经过大量的生产实践检验,采用多种生物技术集成的做法,无论是日常控制弧菌,还是在弧菌爆发情况下,快速控制弧菌,在养殖生产实际中,对苗池、标粗池、养成池的弧菌控制,都取得了良好的效果。
从防治的角度看
弧菌病:可以预防与治疗,并且治疗有效。
病毒病:只可以预防,治疗基本无效。
所以,尽管许多水产养殖者视弧菌为南美白对虾养殖的“一杀手”,但个人看来,相对于病毒病,还不是那么“吓人”。及时发现、及时治疗,是可以得到管控的。
我们建议,在水体监测中,采用总菌数与弧菌数同时定期监测,及时分析的做法。可以做到及时发现弧菌预警,提前调整预防和控制措施。
据科研数据表明,当所测绿菌达弧菌总数1/3以上的塘,80%的虾塘会爆发疾病。所以,在实际生产中也是可以参考的一个重要指标。
秋季对虾病害的预防方法
入秋以后,南美白对虾养殖与夏季高温期有了很大差异。随着昼夜温差加大大,水质变化也较大,因此,对虾应激大,易诱发弧菌病和病毒病。
在变温期,尤其是水温在24~26℃之间,如转季的4、5月份,以及9、10月份,这四个月是病毒、弧菌爆发集中的月份。对虾肠炎、偷死、白便也是这个季节的高发病害。一旦对虾肝胰腺出现问题,抵抗力就会随之下降,弧菌、病毒易感染,造成多种疾病同时并发,治疗相当困难。
具体做法建议:
1、秋虾、冬棚虾放苗,还是在虾苗的选择上要慎重、慎重、再慎重。因为,这一部分经常不掌握在养成塘的养殖场手中,有的时候只能是“被选择”。不管如何,还是要在苗场、苗种、批次上多加考虑。
2、入秋后,水质由于季节性的水体中藻类、菌类的快速变化,各种指标也会快速变化。这对养殖过程中的水质稳定和水体溶解氧含量保持影响很大,也是这一阶段的关键。水质稳定和充足的溶氧,意味着水体保持着适于白对虾健康生长的状态,利于致病菌抵御。
3、合理投喂营养均衡的饲料,及时补充多维电解质,拌喂有益菌以保肝健肠,保持白对虾健康状态,是抵御疾病关键的体质保证。
4、采取有效的生物措施,尽量不使用抗生素等药物,建立适于白对虾自身抗病能力提高的稳定生物环境。一是减少/控制致病菌在养殖水体中的比例,使其无法达到致病临界值;二是减少/控制/抵抗致病菌在白对虾体内的致病作用。这就要求白对虾的肝胰腺、肠道保持健康状态,对致病菌的抵抗力提高。
生物控制弧菌
既然弧菌是水体中的常见菌,我们也就没必要非要“杀灭”弧菌,况且实际上我们也办不到。
换一个思路:采取一些方法,将弧菌控制在“不致病”的范围内,只要不影响对虾生长就可以了。 因此,尽量采取一些生物技术集成,保持对虾相对的“自然状态”,更有利于建立水生动物自身的疾病抵抗力。
建议:
1、 放养健康的虾苗,减少因弱苗导致虾易感病菌的情况。
2、 放苗后,就要定期检测弧菌,将这个工作作为日常管理程序执行。建议每周检测一次,这是一般养殖场可以接受的操作。
3、 检测做记录,与其它水质测定、微生物测定数据做分析。
4、 控制弧菌,尽量采用菌相+藻相+蛭弧菌的生物控制方案。不到非用不可,避免使用消毒剂。
5、 水质和底质管理是弧菌防控的关键。不良的水体,才会诱发弧菌危害。
6、 加大增氧,提高水体溶解氧含量,对控制弧菌有明显效果。
这是噬菌蛭弧菌进入弧菌细胞内,并形成四个增殖体,将弧菌细胞破坏的生物学机制模型图示。
目前,利用微生物进行水质处理与病害防治,业已证明是一种绿色环保、有效的病害防治技术与方法,在国内外均有大量的报道。“生物防治”,由于现代生物技术的快速进步,正在成为一种“行之有效”的措施。
近些年,我们经过大量的生产实践检验,采用多种生物技术集成的做法,无论是日常控制弧菌,还是在弧菌爆发情况下,快速控制弧菌,在养殖生产实际中,对苗池、标粗池、养成池的弧菌控制,都取得了良好的效果。